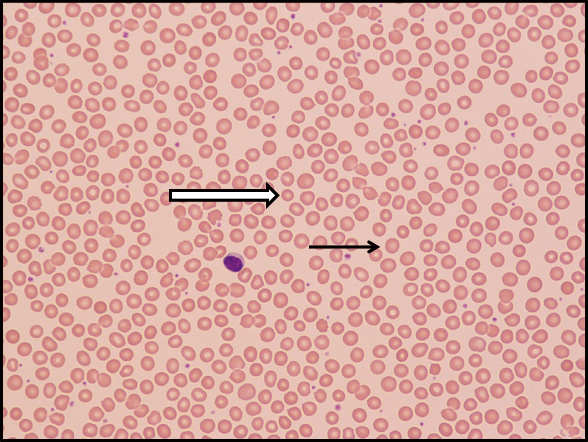

=== 随筆・その他 ===
|
倦怠感・やる気がでない・がんばれない・
動悸・時々たちくらみ・食欲不振 |
東区・郡元支部
(デイジークリニック) 武元 良整 |
|
ありがちな主訴です。外来では「multi-complaints」として悩みます。ところが,血液生化学検査にて潜在的鉄欠乏(低フェリチン)が判明し血液塗抹標本の赤血球像の観察が鉄欠乏状態の診断に有用であった症例を呈示します。
症 例:46歳,女性
主 訴:倦怠感・やる気がでない・がんばれない・動悸・時々たちくらみ・食欲不振
背 景:1年前,鉄欠乏性貧血と診断され鉄剤静注にて貧血は回復。
本人は上記症状から「貧血の再発」を心配して来院。3カ月前から食欲不振。
血液検査施行前
問診,診察から以下の可能性を疑い検査計画しました。
1.年齢から「更年期障害」
2.今年は猛暑だったことから「夏バテ」「ビタミンB12欠乏」
3.内分泌的には「甲状腺機能異常」
4.内科的に倦怠感は「肝機能障害」
5.動悸から「パニック障害など自律神経異常」
6.たちくらみから「起立性循環障害,低血圧」
7.既往歴から「鉄欠乏性貧血再発」
8.食欲不振から,ピロリ菌感染の疑い
9.消化器,婦人科疾患の精査必要
迅速末梢血検査施行後
外来時迅速検査は鉄欠乏性貧血再発を疑い施行,結果は以下。
検査結果
| RBC:477/μL,Hb:14.7g/dL,MCV(mean corpuscular volume:平均赤血球容積):92.0fL,MCH(mean corpuscular hemoglobin:平均赤血球血色素値):30.8pg,PLT(血小板数):31.4万/μL |
迅速結果から貧血の可能性はHb値が14.7であることから否定。なぜなら,Hb濃度の低下が貧血です。その値は個人によって変動しますが,正常値の基準は小児および妊婦ではHb濃度11g/dL以上,思春期および成人女性では12g/dL以上,成人男性では13g/dL以上とされています1)。ところが,血清鉄と血清フェリチン値の翌日報告ではそれぞれ81μg/dLと8.8ng/mLでした。Hbは正常,低フェリチンから「潜在的鉄欠乏」2)と判断しました。潜在的鉄欠乏とはHb>12.0だが,低フェリチン<12.0と規定されています。末梢血液像を観察すると赤血球の形態は図1のように大小不同1+あり,多染性1+でした。つまり,貧血回復期です。その後,血清ビタミンB12:146pg/mL(基準値180-914pg/mL)と低値が判明。
経 過:多様な主訴はこの「低フェリチン」と「ビタミンB12欠乏」が原因と考えました。ビタミンB12欠乏の自覚症状は3)たちくらみ,倦怠感など多様です。現在,治療中です。消化器,婦人科,甲状腺疾患はすでに受診し,異常ありません。
まとめ
「倦怠感・やる気がでない・がんばれない・動悸・時々たちくらみ・食欲不振」という訴えは血液生化学検査から潜在的鉄欠乏(フェリチン低値)とビタミンB12欠乏と診断。Hb値が正常でも貯蔵鉄としてのフェリチンの検査が有用で,末梢血液像では小球性低色素性の赤血球が散見されることから潜在的鉄欠乏を再確認できた症例をご報告いたしました。
文 献
1.成田美和子:貧血の分類と診断の進め方,日内会誌 104:1375-1382.2015
2.張替秀郎:鉄代謝と鉄欠乏性貧血-最近の知見-,日内会誌 104:1383-1388.2015
3.武元良整:健診で貧血を指摘されて(1)~2年間,自覚症状のなかった鉄欠乏性貧血~,鹿児島県医師会報 平成28年9月号:65-67.2016
|
図1 末梢血液像(⇒:小球性低色素性赤血球が散在,→:正球性正色素性赤血球)
(末梢血液画像は鹿児島市医師会臨床検査センター血液検査室へ依頼し撮影していただきました) |

|
|
このサイトの文章、画像などを許可なく保存、転載する事を禁止します。
(C)Kagoshima City Medical Association 2016 |